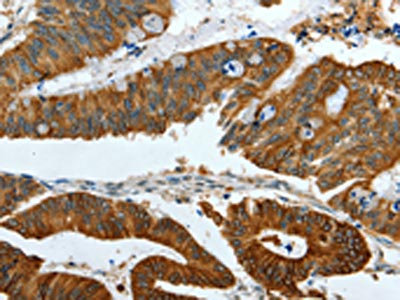

-
中文名稱:KRT19兔多克隆抗體
-
貨號:CSB-PA909758
-
規格:¥1100
-
圖片:
-
The image on the left is immunohistochemistry of paraffin-embedded Human thyroid cancer tissue using CSB-PA909758(KRT19 Antibody) at dilution 1/15, on the right is treated with fusion protein. (Original magnification: ×200)
-
The image on the left is immunohistochemistry of paraffin-embedded Human colon cancer tissue using CSB-PA909758(KRT19 Antibody) at dilution 1/15, on the right is treated with fusion protein. (Original magnification: ×200)
-
Gel: 12%SDS-PAGE, Lysate: 40 μg, Lane 1-2: Hela cells, lovo cells, Primary antibody: CSB-PA909758(KRT19 Antibody) at dilution 1/1000, Secondary antibody: Goat anti rabbit IgG at 1/8000 dilution, Exposure time: 50 seconds
-
-
其他:
產品詳情
-
Uniprot No.:
-
基因名:
-
別名:40 kDa keratin intermediate filament antibody; CK 19 antibody; CK-19 antibody; CK19 antibody; Cytokeratin 19 antibody; Cytokeratin-19 antibody; K19 antibody; K1C19_HUMAN antibody; K1CS antibody; Keratin 19 antibody; Keratin type I 40 kD antibody; Keratin type I 40kD antibody; Keratin type I cytoskeletal 19 antibody; Keratin, type I cytoskeletal 19 antibody; Keratin, type I, 40 kd antibody; Keratin-19 antibody; KRT19 antibody; MGC15366 antibody
-
宿主:Rabbit
-
反應種屬:Human,Mouse,Rat
-
免疫原:Fusion protein of Human KRT19
-
免疫原種屬:Homo sapiens (Human)
-
標記方式:Non-conjugated
-
抗體亞型:IgG
-
純化方式:Antigen affinity purification
-
濃度:It differs from different batches. Please contact us to confirm it.
-
保存緩沖液:-20°C, pH7.4 PBS, 0.05% NaN3, 40% Glycerol
-
產品提供形式:Liquid
-
應用范圍:ELISA,WB,IHC
-
推薦稀釋比:
Application Recommended Dilution ELISA 1:2000-1:5000 WB 1:500-1:2000 IHC 1:25-1:100 -
Protocols:
-
儲存條件:Upon receipt, store at -20°C or -80°C. Avoid repeated freeze.
-
貨期:Basically, we can dispatch the products out in 1-3 working days after receiving your orders. Delivery time maybe differs from different purchasing way or location, please kindly consult your local distributors for specific delivery time.
-
用途:For Research Use Only. Not for use in diagnostic or therapeutic procedures.
相關產品
靶點詳情
-
功能:Involved in the organization of myofibers. Together with KRT8, helps to link the contractile apparatus to dystrophin at the costameres of striated muscle.
-
基因功能參考文獻:
- elevated level of preoperative serum Cyfra 21-1 indicates an advanced stage of tumor PMID: 30037371
- CYFRA 21-1 assessed at the end of RT or ChT seems to be a prognostic marker for tumor response. A high concentration of CYFRA 21-1 after treatment increases the risk of death. CYFRA 21-1 might be suggested in the monitoring of carcinomas of head and neck cancer (HNC). PMID: 28604997
- the modulation of KRT19 expression could be involved in cancer stem cell reprogramming and drug sensitivity. PMID: 29747452
- High expression of CK-19 is associated with intrahepatic cholangiocarcinoma. PMID: 29513894
- KRT19 intracellularly binds to HER2, playing a critical role in HER2 activation PMID: 28008968
- The combined use of CK19 and CD56 is helpful in discriminating papillary thyroid carcinoma and its variants from other mimicking thyroid lesions. PMID: 28214214
- CYFRA 21-1 can be useful as a tumor marker for evaluating tumor progression and treatment efficacy in patients with extramammary Paget's disease. PMID: 28150330
- YAP1 activation was more commonly found in CCAs than in pure HCCs. However, a differing pattern of YAP1 expression between cHC-CCAs and CK19(+) HCCs and the poor prognosis of YAP1 positive hepatic carcinomas suggests that YAP1 may have a preferential role in aggressive tumor behavior, rather than in the determination of cellular lineage in hepatic carcinomas PMID: 28645247
- Circulating tumor cells expressing cytokeratin and tumor-initiating cell markers, including ALDH, CD133, and CD44, were identified in patients with pancreatic adenocarcinoma. These TIC-like CTCs were associated with poor prognosis after surgical resection and with an increased incidence of tumor recurrence PMID: 27789528
- Aberrant decreased miR-26a could promote cell proliferation by regulating KRT19 which plays important role in the pathogenesis of cholangiocarcinoma. PMID: 27833076
- The detection of TK1 combined with that of cytokeratin-19 fragment (CYFRA21-1), CEA or NSE increased the diagnostic value of TK1 for lung squamous cell carcinoma, adenocarcinoma and small cell lung cancer, respectively. PMID: 29247745
- Our results are of special importance against the background that CK19 positive carcinomas revealed a significantly poorer prognosis and therefore emphasize its prognostic and possible diagnostic role in tongue cancer. PMID: 27764819
- (18)F-FDG-PET can be used to predict K19 expression in hepatocellular carcinoma and should thereby aid in the development of novel therapeutic strategies targeting K19(+) hepatocellular carcinoma cancer stem cells PMID: 27663597
- Immunohistochemical assessment of both CK19 and SCCAg status in histologically negative sentinel lymph nodes may be a valuable approach for predicting recurrence and survival after curative surgery for cervical squamous cell carcinoma. PMID: 27654256
- Positive CK-19 expression can be used as a predictor of poor prognosis of PNET PMID: 29136022
- Data suggest that high cytokeratin 19 (CK19) levels in peripheral blood may independently predict non-sentinel lymph node (nSLN) metastasis in breast cancer patients. PMID: 27105542
- Findings provide evidence that K19 expression is inducible in human hepatocellular carcinoma as a sign of tumor progression. PMID: 28783171
- Urine levels of COL4A1, COL13A1, the combined values of COL4A1 and COL13A1 (COL4A1 + COL13A1), and CYFRA21-1 were significantly elevated in urine from patients with BCa compared to the controls. A high urinary COL4A1 + COL13A1 was found to be an independent risk factor for intravesical recurrence. PMID: 28837258
- CK19 and carcinoembryonic antigen may be involved in lymph node metastasis and poor prognosis in patients with gastriccardia cancer PMID: 28293089
- The study has confirmed the preservation of CK19 protein expression in breast cancer cells after neoadjuvant therapy. On the basis of these results, quantification-based methods such as the one-step nucleic acid amplification (OSNA) CK19 assay, could be an accurate tool with which to analyse the sentinel nodes, regardless of whether they had been obtained before or after treatment. PMID: 26708058
- Serum CYFRA 21-1 level may be a predictive factor for patients with non-small cell lung cancers treated with EGFR-TKIs, regardless of EGFR mutation status. PMID: 28982900
- Data suggest that keratin (K) 19 (K19) may be a drug target for the treatment of K19-positive hepatocellular carcinoma (HCC). PMID: 27863477
- Combination of the two tumor markers, CEA and CYFRA21-1, is a predictive and prognostic marker of docetaxel monotherapy for previously treated NSCLC patients PMID: 28870944
- Results suggest that positive expression of CK19 mRNA and TK1 protein is closely correlated with poor prognosis in advanced gastrointestinal cancer. PMID: 27625087
- GPC3 and KRT19 overexpression are associated with carcinogenesis, progression, and poor prognosis in patients with PDAC and a valuable biomarker for diagnosis of PDAC. PMID: 27689616
- Data show that sixty one patients with a high cytokeratin 19 fragment (CYFRA 21-1) level had statistically shorter progression-free and overall survival than 39 patients with a normal CYFRA 21-1 level . PMID: 28179355
- Data indicate that serum tumor markers showed significant shorter 3-year progression-free survival (PFS) in higher levels compared to lower levels for S-CYFRA 21-1 (cytokeratin 19 fragment), S-SCCA and S-CEA. PMID: 26432331
- Gene promoter hypermethylation is found in sentinel lymph nodes of breast cancer patients identified as positive by one-step nucleic acid amplification of cytokeratin 19 mRNA PMID: 27097811
- Peritumoral ductular reaction was more abundant and proliferative in CK19+ hepatocellular carcinoma patients, with higher level of nuclear translocation of beta-catenin. PMID: 27049492
- BALF and serum NSE, CEA, and CYFRA21.1 elevated in lung cancer, which had prompt value for pathology, especially significant for BALF. PMID: 27072263
- Significant levels of CEA, CYFRA 21-1, NSE, and TSGF were detected in the serum. The amounts found were useful for diagnosing non-small cell lung cancer (NSCLC) patients who depended on the currently limited biomarker development. PMID: 27072222
- The cytologic tumor marker c-CYFRA was positively associated with EGFR mutations in non-small cell lung cancer (NSCLC). EGFR mutation-positive NSCLCs have relatively lower glycolysis compared with NSCLCs without EGFR mutation PMID: 26979333
- Results show that serum miR21 could serve as an important marker for auxiliary diagnosis of early non-small cell lung cancer (NSCLC), while joint detection of serums miR21 and CYFRA21-1 levels could improve diagnostic efficiency. PMID: 26880855
- Positive staining for CK19 suggests a possible LPC origin of the EpCAM positive hepatocellular carcinoma . PMID: 26609030
- Increased Expression of K19 mRNA is associated with Recurrence After Curative Resection of Hepatocellular Carcinoma. PMID: 25791790
- Patients with CK19 positivity showed a higher prevalence of microvessel invasion than those without CK19. PMID: 26212571
- We report results of the studies relating to fabrication of a non-invasive, label-free and an efficient biosensing platform for detection of the oral cancer biomarker (CYFRA-21-1). PMID: 26657594
- Serum CYFRA21-1 and CEA can be used as prognostic factors of NSCLC patients. Combinative detection of the two indices will be more reliable. PMID: 26333429
- Data show that serum neuron-specific enolase, cytokeratin 19 fragment 21-1, pro-gastrin-releasing peptide, squamous cell carcinoma antigen, tissue inhibitor of metalloproteinase-1, and human epididymis protein 4 are not associated with brain metastases. PMID: 26730601
- CK19 expression was measured in hepatocellular carcinoma at different stages and correlated with prognosis. CK19+/GPC3+ HCC has the highest risk of intrahepatic metastasis, microvascular invasion, regional lymph node involvement, and distant metastasis. PMID: 26977595
- CK19 staining was found in hepatic hydatidosis patients with and without biliary fistula. PMID: 27141570
- When confirmed by a low alpha-fetoprotein concentration (<400 mug/L), CK-19 expression in is an additional valuable indicator of early recurrence, distant metastasis, and poor prognosis in HBV-positive patients PMID: 26588210
- Study confirms the prognostic significance of K19 expression in Caucasian patients with hepatocellular carcinoma. PMID: 26011233
- High serum levels of CYFRA 21-1 are associated with oral squamous cell carcinoma. PMID: 26292957
- K19 is a new cancer stem cell marker associated with epithelial mesechymal transformation and TGFb/Smad signaling. PMID: 25820415
- Elevation of serum CYFRA21-1 is associated with Non-small Cell Lung Cancer. PMID: 26163610
- Postoperative CK19-2G2 concentration may be an indicator of prognosis. An increase after the initial drop in CK19-2G2 concentration after surgery may indicate a poor prognosis. PMID: 26002573
- CK19 and HBME-1 were significantly expressed more in papillary carcinoma as compared to follicular carcinoma PMID: 26503236
- CK19 mRNA expression in peripheral blood was evaluated by qRT-PCR as an index of circulating tumor cells in 15 cases of HER-2-positive breast cancer and 18 cases of HER2-negative breast cancer PMID: 25867356
- CK19 proved to be a sensitive marker to identify yolk sac tumours of the testis and to distinguish them from other germ cell tumours. PMID: 25889715
顯示更多
收起更多
-
蛋白家族:Intermediate filament family
-
組織特異性:Expressed in a defined zone of basal keratinocytes in the deep outer root sheath of hair follicles. Also observed in sweat gland and mammary gland ductal and secretory cells, bile ducts, gastrointestinal tract, bladder urothelium, oral epithelia, esophagu
-
數據庫鏈接:
Most popular with customers
-
-
YWHAB Recombinant Monoclonal Antibody
Applications: ELISA, WB, IHC, IF, FC
Species Reactivity: Human, Mouse, Rat
-
Phospho-YAP1 (S127) Recombinant Monoclonal Antibody
Applications: ELISA, WB, IHC
Species Reactivity: Human
-
-
-
-
-